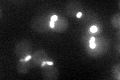
YDL225W
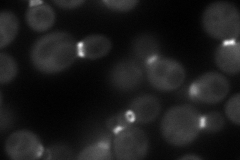
YDL225W
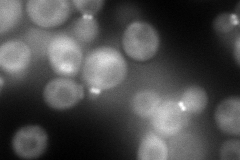
YDL225W
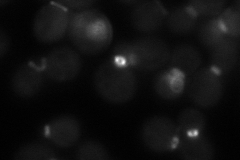
YDL225W
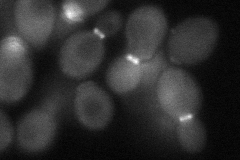
YDL225W
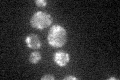
YDL225W

View description
One of five related septins (Cdc3p, Cdc10p, Cdc11p, Cdc12p, Shs1p) that form a cortical filamentous collar at the mother-bud neck which is necessary for normal morphogenesis and cytokinesis
Localization:
Intensity:
Fold change:
Significance:
-
C’ GFP library in SD
bud neck -
N' NOP1pr-GFP in SD
bud neck119.192 -
N' TEF2pr-mCherry in SD
cytosol,bud neck157.842 -
N' NATIVEpr-GFP in SD
bud neck47.5 -
N' TEF2pr-VC and Cyto-VN in SD
bud neck53.7862 -
C’ GFP library in SD+DTT

bud neck41.981.15No -
C’ GFP library in SD+H2O2

bud neck36.170.99No -
C’ GFP library in Starvation Media
punctateN/AN/AYes -
C’ GFP library on the background of Pup2-DaMP

bud neck -
C’ GFP library on the background of CCT mutant

bud neck44.40661.22295No
